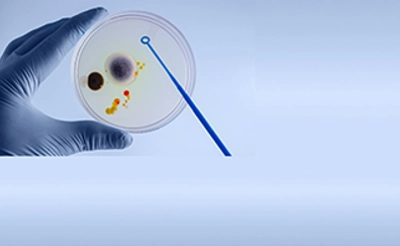

Additivo inibitore di corrosione per benzina e compatibilizzante per componenti ossigenati

Additivo professionale per cleaning e decontaminazione dei serbatoi gasolio

La linea di additivi biocida per eliminare e prevenire la contaminazione microbiologica nei carburanti.

Flow Improver WAFI per la massima operabilità del gasolio invernale

Additivo multifunzionale per migliorare la qualità del gasolio

Gruppi elettrogeni e gasolio pulito per garantire continuità operativa nei momenti di crisi.

Il software di gestione rifornimenti Piusi, ideale per le PMI

Filtrazione fluidi

Una soluzione efficace per l’abbattimento della carica microbiologica

Rifornimento AdBlue

La contaminazione del gasolio

La contaminazione microbica nelle imbarcazioni

DEPURdiesel

La Contaminazione del Gasolio

Motori e Carburanti

Quali sono le principali cause della contaminazione microbica e come contrastarle

Sistemi di filtrazione e depurazione del gasolio EN590 per macchinari e cisterne

Biocidi di nuova generazione per la risoluzione delle problematiche di contaminazione batterica del gasolio

La principale causa di malfunzionamenti e guasti in qualunque impianto/macchina oleodinamica